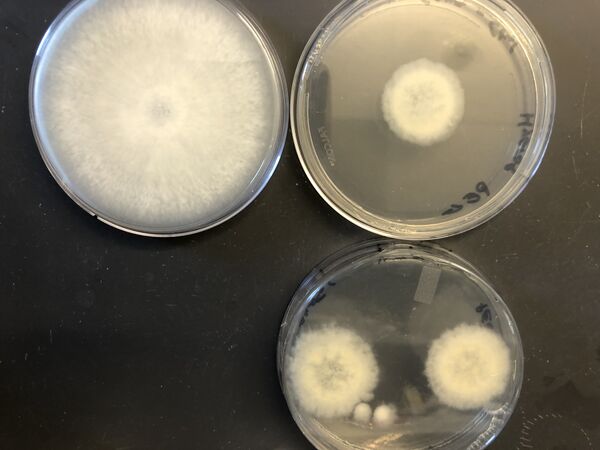

Plasmid delivery using PEG-mediated transformation
From OpenWetWare
Jump to navigationJump to search
- Inoculate 50 mL PDY or MPDY in a 125 mL flask with 9 plugs of leading edge tissue. Culture at 30C, 70 rpm for 5 days.
- Prepare 20ml of lysing enzymes (0.04g/ml of Lysing Enzyme from Trichoderma harzanium in 0.6 M KCl, 0.1 M phosphate buffer pH 5.8) and incubate 15min at 37C, 200 rpm (use a 50 ml tube)
- Collect 5 day old mycelium from the flask using a 40um filter and wash it using 10ml of 0.6 M KCl, 0.1 M phosphate buffer pH 5.8 (use a 50 ml tube and 40 um filter).
- A second wash can sometimes improve yield with older cultures: resuspend the mycelia in 10ml of 0.6 M KCl, 0.1 M phosphate buffer pH 5.8 in a 50 mL conical tube, vortex, and then centrifuge at 6k rpm for 5 minutes. Discard the supernatant.
- Transfer the mycelium into a single 125 ml flask,
- Filter lysing enzymes (0.2um syringe filter) and add the enzyme to the flask with mycelia. Incubate for 3-4h, 25C, 70 rpm.
- Collect 10 µL and check for protoplast formation.
- Filter the protoplasts through sterile cheese cloth stuffed into a 60 mL syringe that is directed into a 40um cell filter over a 50 mL conical tube.
- If needed filter through a 5 um MILLEX syringe filter into a clean conical tube.
- Collect the protoplasts by centrifugation, 3500 rpm, 4C
- Discard the supernatant and wash the protoplasts using 10ml of TMS
- Collect the protoplasts by centrifugation, 3500 rpm, 4C
- Discard the supernatant and resuspend the protoplast into 300ul of TMSC
- Count the protoplasts
- Using microscope at 40x and Neubauer improved 0.1mm 0.0025 mm^2
- Image all four large corner squares each composed of 16 small squares.
- Using Fiji count protoplasts in all 64 squares.
- http://insilico.ehu.eus/counting_chamber/neubauer_improved.php
- https://www.emsdiasum.com/microscopy/technical/datasheet/68052-14.aspx
- Adjust the protoplast to 2.10^7 protoplasts / 100ul
- Prepare the DNA solution :
- 5ug plasmid into 30ul of H2O + 30 ul of TE CaCl2 2x. optional: add 10µg single stranded Salmon Sperm DNA as carrier DNA
- Add the 60ul DNA solution into the 100ul of protoplasts and incubate 20 min in ice
- Dilute 1.2g of PEG 6000 into 800ul MS (per sample), microwave approximately 1min, until mix becomes clear and contains no precipitates (do not overheat, mix will turn cloudy), then cool down at RT
- Add the 800ul PEG into the 160ul protoplast + DNA
- Mix gently and incubate 15min at RT
- Add 1ml of TMSC into the PEG-protoplast solution
- Centrifuge 5min at 5000rpm (minispin)
- Discard the supernatant and resuspend the pellet into 400ul of TMSC
- Add 100 µL of PDY or MPDY into the 400 ul of protoplast solution and incubate on the barrel rotator in the 30C incubator for one hour.
- Pour the solution on 1 plate of PDYA or MPDYA + fungicide (Carboxine 20ug/ml or hygromycin 100 ug/ul).
- Incubate the plate in darkness at 30C.
- Transfer tissue segments from putative transformants to new selection plates.
- Complete at least three rounds of selection.
- Confirm transformation via PCR of gDNA and amplicon sequencing.
- For top agar selection method:
- Add 100ul of the protoplasts solution into 3ml of MMV top media (keep the MMV top at 42C before adding the protoplasts )
- Vortex 2sec and pour the solution on 1 plate of MMV + fungicide
- Incubate the plate at 30C.